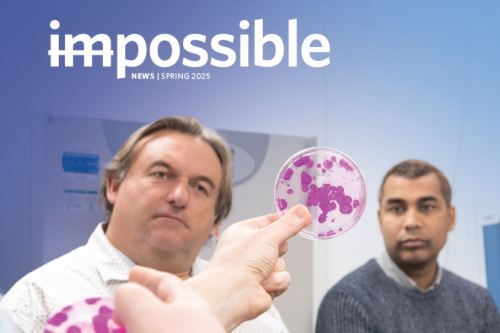

News & stories
imPossible: Spring 2025 newsletter
23 September 2025
Read about all the latest news and updates at The Alfred Foundation in the Spring 2025 edition of imPossible, thanks to the support of you, in our community.
burns
cancer
community fundraising
emergency & trauma
leukaemia
patients
philanthropy
radiation therapy
research & innovation
staff
the alfred foundation
vabs

Critical Care Appeal raising lifesaving funds for Mobile ECPR
5 September 2025
This year’s Critical Care Appeal is fundraising to support Mobile ECPR, an advanced form of life support which takes over the function of the heart and lungs for patients in the community after cardiac arrest.
ecmo
fundraising
heart failure
-08_500_333.jpg)
New hope for silicosis sufferers
8 August 2025
New hope is on the horizon for silicosis sufferers with Melbourne experts set to embark on a world-first trial aiming to halt progression of the deadly lung disease.
research & innovation
the alfred foundation

A new look at wellness
7 July 2025
The opening of the Paula Fox Melanoma and Cancer Centre in 2024 marked a monumental leap forward in the integration of cutting-edge research, clinical care and innovative cancer treatments.
cancer
melanoma
oncology
patients
research & innovation
staff
the alfred foundation

World-first trial in silicosis
10 June 2025
Patients around the globe who suffer from silicosis - a potentially fatal lung disease - are a step closer to a viable treatment for the disease, thanks to a three-year research funding commitment from Zaparas Lawyers.
lung
patients
research & innovation
staff
the alfred foundation

This new trauma bay will save lives at The Alfred
27 May 2025
By the time that George was flown 140km by helicopter to The Alfred from Cressy, west of Geelong, he needed medical attention – fast.
emergency & trauma
patients
research & innovation
staff
the alfred foundation

Out of the box thinking
21 May 2025
It may look like just an ordinary black box, but this cutting-edge machine could lead to remarkable discoveries in cancer research through its capabilities in synthetic biology and genetic engineering.
cancer
patients
research & innovation
staff
the alfred foundation

ECMO in the community - a groundbreaking approach
9 May 2025
The Alfred is the first hospital in Australasia to incorporate a revolutionary clinical trial using portable cardiopulmonary bypass machines outside of the hospital.
ecmo
emergency & trauma
patients
research & innovation
staff
the alfred foundation

‘Potentially groundbreaking’ gift for sarcoma research
2 May 2025
The prospect of “potentially huge breakthroughs” in sarcoma research at The Alfred will be much greater, thanks to a future donation.
cancer
patients
research & innovation
staff
the alfred foundation

Robot Royce moves into action
17 April 2025
A special new starter joined The Alfred surgery team in February, with ‘Royce’ the surgical robot performing its first cases.
cancer
patients
research & innovation
staff
surgery
the alfred foundation